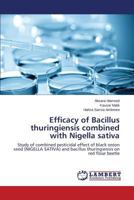
Efficacy of Bacillus Thuringiensis Combined with Nigella Sativa 3847311980 Book Cover

Most Popular Books
- Efficacy of Bacillus Thuringiensis Combined with Nigella Sativa
- Prevalenza dei fattori genetici e ambientali nella cataratta congenita (Italian Edition)
- Prävalenz genetischer und umweltbedingter Faktoren bei angeborener Katarakt (German Edition)
- Czestosc wystepowania czynników genetycznych i srodowiskowych w przypadku zacmy wrodzonej (Polish Edition)
- Prevalência de fatores genéticos e ambientais na catarata congénita (Portuguese Edition)